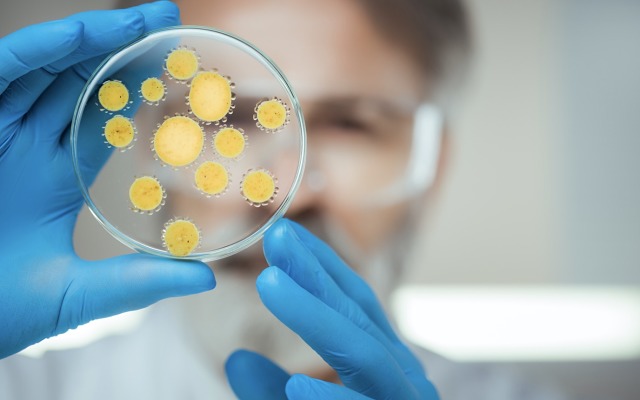
Botanix Pharmaceuticals receives FDA grant for antibacterial product BTX 1801

Amid the difficulties created by the COVID-19 pandemic, synthetic cannabinoid company Botanix Pharmaceuticals (ASX: BOT) unveiled an operational boost in the form of support from the US FDA to fast track its first antibacterial product BTX 1801.
Earlier today, the company announced that the FDA’s Office of Antimicrobial Products had granted BTX 1801 – a treatment to prevent post-surgical infections – what’s known as qualified infectious disease product (QIDP) status which means Botanix can receive a variety of incentives as part of its drug development program.
The most highly coveted incentive afforded to products with QIDP status is an additional five years of regulatory exclusivity, on top of the standard exclusivity that is afforded to new drugs as part of the FDA’s approval procedure.
Extending exclusivity significantly increases the commercial value of a successful product primarily because other generic drugs are prevented from entering the market.
Furthermore, successful QIDP recipients are also eligible for priority review status that expedites the FDA’s review period, from the standard 12 months to around six months.
The race to develop better antibiotic products is becoming ever more important given the growing issue of antibiotic resistance. The UN estimates that the ongoing development of resistance to antibiotics could lead to 10 million deaths every year by 2050 and economic losses of US$100 trillion if new antibiotics are not found.
According to the UN, Staph and MRSA are the most troublesome resistance forming bacteria worldwide and are the leading cause of post-surgical infections and surgical site infections.
“Better infection prevention measures are desperately needed in surgical settings to combat the growing global development of antibiotic resistance. Nasal decolonisation agents like BTX 1801 may represent a front-line approach towards reducing post-surgical infections, improving patient outcomes and overall reducing the economic burden on the healthcare system,” said Professor Geoffrey Coombs, president of the Australian Society for Antimicrobials and chair of public health at Murdoch University.
Support base
QIDP is specifically reserved for products that fulfil a strict set of qualifying criteria and requires the provision of a detailed package of supporting data to the FDA and must demonstrate the product’s novelty and potential to treat a serious or life-threatening disease.
With the grant received, Botanix president and executive chairman Vince Ippolito said he expects the company to go a step further by applying for fast-track status “during this quarter, with the hope of accelerating the path to market”.
Fast-track designation enables Botanix to have more frequent communication with the FDA during the drug development and review process, thereby enabling valuable guidance to be included in its development program.
“This achievement is built on the back of solid pre-clinical research that demonstrates to the FDA that BTX 1801 has the potential to prevent post-surgical infections,” said Mr Ippolito.
According to Botanix, it provided a detailed data package which allowed the FDA to assess both the activity of BTX 1801 and the serious or life-threatening nature of the indication Botanix is targeting.
In terms of conducting clinical studies, just last month Botanic received ethics approval to conduct a phase 2a study to evaluate the safety, tolerability and efficacy of two formulations of BTX 1801, specifically to decolonise staphylococcus aureus and methicillin-resistant staphylococcus aureus, better known as MRSA or Golden Staph from the nose of healthy adults.
The clinical study could potentially be postponed due to existing travel restrictions across Australia, although Botanix said it was “confident” that as soon as travel requirements within Western Australia are eased recruitment will resume, allowing the study to potentially be completed in the third quarter of this year.
News of an FDA grant boosted Botanix shares by over 70% to $0.058 in morning trade.